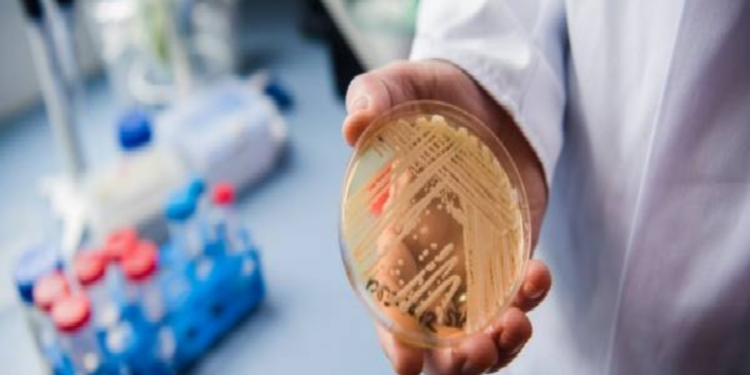

அமெரிக்காவில் மனிதர்களின் உயிரை பறிக்கும் ‛கேண்டிடா ஆரிஸ் எனும் பூஞ்சை தொற்று பரவ தொடங்கியுள்ளது.
இதனால் பொதுமக்கள் அச்சமடைந்துள்ள நிலையில் பூஞ்சை தொற்று பாதித்தால் என்ன நடக்கும் என்பது பற்றிய திடுக்கிடும் தகவல் வெளியாகி உள்ளது.
2019 ஆம் ஆண்டு இறுதியில் சீனாவில் கொரோனா வைரஸ் பரவ தொடங்கியது. இந்த வைரஸ் அடுத்த 2 ஆண்டுகளில் உலகம் முழுவதும் பரவி மொத்தமாக மனிதர்களை முடக்கியது. இந்த வைரஸ் பாதிப்பில் இருந்து மக்கள் மீண்டு வருகின்றனர்.
இந்நிலையில் தான் அமெரிக்காவில் தற்போது ‛கேண்டிடா ஆரிஸ் எனும் பூஞ்சை தொற்று வேகமாக பரவ தொடங்கி உள்ளதாக கூறப்படுகிறது. இந்த பூஞ்சை தொற்று என்பது மனிதர்களின் உயிரை பறிக்கும் திறனை அதிகம் கொண்டுள்ளதால் அமெரிக்க மக்கள் அதிர்ச்சியில் உள்ளனர்.
அதாவது அமெரிக்காவின் வொஷிங்டனில் கடந்த மாதம் ஒருவருக்கு கேண்டிடா ஆரிஸ் பூஞ்சை தொற்று பாதிப்பு கண்டறியப்பட்டது. அவருக்கு சிகிச்சை அளிக்கப்பட்டு வரும்போதே சியாட்டில் 3 பேருக்கு பாதிப்பு உறுதி செய்யப்பட்டது.
தற்போது வரை 4 பேர் பாதிக்கப்பட்டுள்ள நிலையில் அவர்களுக்கு தீவிர சிகிச்சை அளிக்கப்பட்டு வருகிறது. அமெரிக்காவில் ‛கேண்டிடா ஆரிஸ் பாதிப்பு தற்போது குறைவாக இருந்தாலும் கூட மக்கள் அச்சமடைந்துள்ளனர்
No comments: